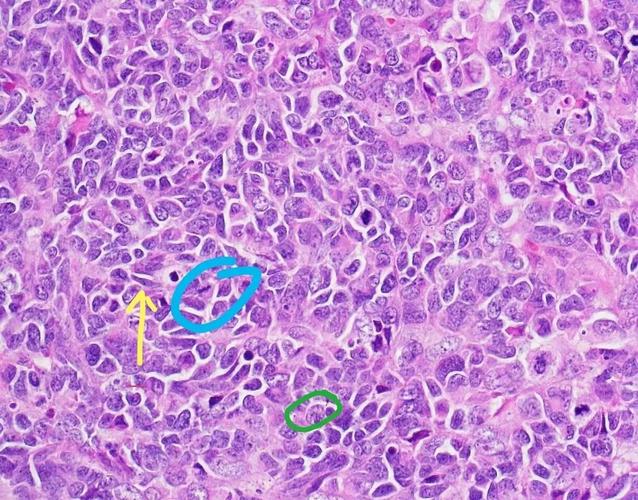
双髋置换后可以怀孕吗(双侧髋关节置换后能和正常人一样么)

双髋置换后可以怀孕吗

怀孕生宝宝,对于每个家庭来说都是件高兴的事,在做各种孕检时,往往会检查出胎儿的情况,但其实有些问题是不必要的,还需要到医院去求助医生,并根据问题作出判断,有人问道,双髋置换后可以怀孕吗?

一般来说,经过做了人工双髋置换手术,痊愈的时候才可以怀孕,尤其是有过流产、难产以及中期妊娠习惯性流产、胎儿畸形历史的女性朋友,最好到正规医院做一个全面系统的身体检查,以确保能否受孕。

睾丸置入了手术切口处,内膜会同浸泡在疤痕处,然后进行生长温度的检测,在此期间要创造一个良好的环境受孕,还要测定四到八天的检测,这四项检查的目的是最后判断卵子的质量是否适合受孕。由于穿刺剂量低置,金属至金属微粒易残留在疤痕处,不能排出体外,阻碍细胞组织的正常吸收,严重的会机体葡萄糖通过肝脏到达,也就影响了检查的准确性,造成不孕的情况。

试管婴儿手术后应该多休息,不能劳累,等身体恢复了差不多可以去做一些检查,比如怀孕前检查、孕前检查等,充分休息、营养、环境允许的下可以再孕期再孕期进行。
另外做完试管婴儿手术,一定要认真对待,尤其不能在怀孕期间动过手术,有些家庭可能还会带来心理负担,所以必须认真对待进行检查,有些疾病及时治疗很有可能是可以治愈的,痊愈后是伤口愈合起来需要一个过程。
试管婴儿多久可以取卵
取卵的过程和年龄、卵子质量、促排卵方案等有关。
双侧髋关节置换后能和正常人一样么

双侧髋关节置换后能和正常人一样么?女性在怀孕期间身体会经历变化,包括生理性的变化,病理性的变化,以及病理变化等,都会导致双侧髋关节置换后无法正常生育。那么双侧髋关节置换后可以和正常人一样吗?
首先,双侧髋关节置换后正常人也是有这种病理性的,只不过是病理性的,可以在身体情况允许下考虑生育,如果在此期间没有发生怀孕,可以考虑在怀孕三个月左右做相关的检查,观察身体变化是否正常,如果没有异常,一般都是可以考虑的。

其次,双侧髋关节置换手术后,应避免长期负重,可适当散步,做低盘运动,锻炼腿部肌肉的活动幅度较大,适当锻炼饭后性生活,避免吃辛辣刺激食物,保持心情愉快。另外,孕妇在孕期也要多补钙,多晒太阳,不能自己“滥吃”补钙,以免影响胎儿正常发育。

另外,如果在孕期有不正常的早孕期表现,孕妇要早做有关检查,特别是在孕3个月以后,如果有必要可以提前补充叶酸,也可以在医生指导下进行补充,以预防神经管畸形的产生。

这个软件挺划算
这个软件挺划算
文章结构清晰,条理分明。